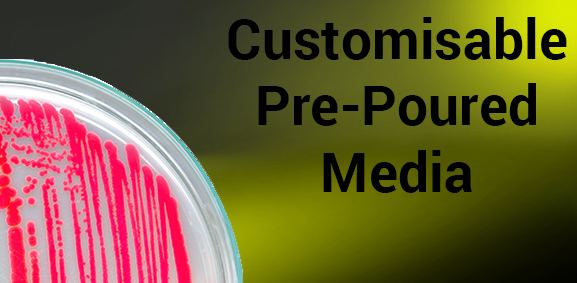

In the fast-moving world of online slot gaming, having a reliable platform where players can test their luck safely and smoothly is a must. Among the top names in the digital gambling landscape, Bensu4D has earned its reputation as a trusted and exciting destination for Toto and slot enthusiasts. However, to truly enjoy everything the site offers, mastering the Bensu4D login process is essential — because your gaming experience starts the moment you sign in.
This guide explores everything you need to know about Bensu4D login, from secure access tips to maximizing your slot play experience. Whether you’re a beginner or a seasoned player, this article will help you unlock the full potential of Bensu4D.
What is Bensu4D?
Before diving into the login process, let’s understand what makes Bensu4D stand out. It’s not just another Toto slot website — it’s a complete gaming ecosystem built for comfort, transparency, and winning opportunities.
Bensu4D combines Toto games, 4D lottery draws, and a wide range of online slot machines from well-known game providers. The platform’s interface is smooth, user-friendly, and designed to deliver a seamless gaming journey. Whether you’re on desktop, tablet, or mobile, the performance remains consistent.
But what truly sets Bensu4D apart is its commitment to player security and fair gameplay. Every spin, every bet, and every draw is protected under a robust system that ensures data privacy and fairness.
The Importance of a Secure Bensu4D Login
In any online platform, especially one that handles money transactions, the login process is your first line of defense. A secure Bensu4D login ensures your funds, identity, and progress remain safe from unauthorized access.
When logging into your Bensu4D account, always make sure you’re visiting the official website. Fake or cloned websites can look similar but are designed to steal user credentials. Bookmark the legitimate Bensu4D link so you never fall into that trap.
Another layer of protection comes from strong passwords and two-factor authentication (2FA), which Bensu4D recommends for all users. Never share your password with anyone and avoid using the same credentials across multiple platforms.
Step-by-Step Guide to Bensu4D Login
Here’s a simple breakdown of how you can log in to your Bensu4D account safely and efficiently:
- Visit the Official Bensu4D Website
Always start by typing the official domain name into your browser’s address bar. Avoid using random links from social media or unverified ads. - Click the Login Button
On the homepage, you’ll see a “Login” or “Masuk” button — usually at the top right corner of the screen. Click it to open the secure login page. - Enter Your Username and Password
Input your registered username and password. Ensure that caps lock is off and your credentials are entered exactly as they were set during registration. - Complete Verification (If Required)
Depending on your account settings, you might be asked to verify your identity via email or SMS code. - Click Submit and Access Your Dashboard
Once logged in, you’ll enter your personal dashboard — your control center for deposits, withdrawals, slot games, and Toto results.
If you’re a new user, you’ll need to register first before logging in. The sign-up process takes just a few minutes and only requires basic details like username, password, and contact information.
Common Login Problems and How to Fix Them
Sometimes, users face minor issues while trying to log in. Here are some common Bensu4D login problems and quick fixes:
- Forgotten Password:
Click on the “Forgot Password” option and follow the instructions to reset it securely. - Account Locked:
After too many failed login attempts, your account may lock temporarily for safety. Wait for 15 minutes and try again or contact customer support. - Wrong Website:
Make sure you’re not on a phishing or fake domain. Always double-check the URL before entering your details. - Browser Cache Issues:
If pages load incorrectly, clear your browser’s cache or try a different browser.
The Bensu4D support team is available 24/7, ready to help resolve login or account-related concerns instantly.
Maximizing Your Experience After Bensu4D Login
Once you’ve successfully logged in, a world of entertainment opens up. The platform offers countless slot games, live draws, and special promotions for loyal members. Here’s how to make the most out of your session:
1. Explore Different Slot Games
Bensu4D hosts hundreds of slot titles, ranging from classic fruit machines to modern video slots with high payouts. Each game comes with unique features like free spins, multipliers, and jackpots.
2. Join the Toto and 4D Draws
Aside from slot gaming, you can participate in daily Toto 4D draws. This adds an extra thrill to your experience and gives you more chances to win big.
3. Take Advantage of Bonuses
After logging in, visit the promotions section. Bensu4D frequently offers welcome bonuses, cashback deals, and referral rewards. Use them wisely to extend your playtime.
4. Manage Your Budget
Responsible gaming is key. Set daily or weekly limits for deposits to keep your gameplay enjoyable and stress-free.
5. Stay Updated
Check the “News” or “Announcement” tab inside your dashboard for new games, maintenance schedules, and tournament events.
Safety Tips for Long-Term Users
If you plan to be an active Bensu4D member, maintaining your account security is vital. Follow these pro tips:
- Update your password regularly.
- Never log in from public Wi-Fi networks.
- Use a trusted antivirus program on your device.
- Log out after every session.
- Avoid saving login details on shared devices.
By following these steps, you’ll ensure that your Bensu4D login remains protected and your gaming experience uninterrupted.
Why Players Trust Bensu4D
Players across Asia and beyond choose Bensu4D for its transparency, fast withdrawals, and engaging slot variety. The brand has maintained a strong reputation through consistent payouts and professional customer service.
Moreover, its platform is licensed and uses SSL encryption to safeguard all user data. This means your transactions, login info, and private details are fully protected under advanced cybersecurity layers.
Conclusion: Bensu4D Login – Your Gateway to Trusted Online Slot Entertainment
At the heart of every exciting Toto or slot adventure is a simple action — logging in securely. With Bensu4D login, you’re not just entering a website; you’re stepping into a community built on trust, innovation, and entertainment.
Whether you’re chasing jackpots or just spinning for fun, Bensu4D ensures a safe, smooth, and rewarding journey from the moment you sign in. Remember, your success begins with secure access — and from there, every spin could bring you closer to your fortune.